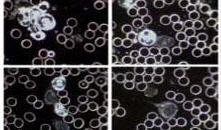

Sie sind hier: Startseite > Behandlungsspektrum > Dunkelfelddiagnose
Dunkelfeld-Diagnose ( nach Prof. Dr. Enderlein )
Die Dunkelfeld-Diagnose ist ein sehr hilfreiches Mittel zur Früherkennung von
eventuellen Soffwechselerkrankungen. Neben den allgemein bekannten
Blutzellen befinden sich unzählige kleinste Mikroorganismen, die sich zu
größeren Körperchen unterschiedlichster Gestalt, vielfach zu Bakterien und
in einigen Fällen sogar zu Pilzen zusammenschieben können.

|
|
Mithilfe eines speziellen Mikroskops ist es möglich, genaueren Aufschluss
über das innere Millieu und die Funktion der Blutzellen zu erhalten. Somit
gibt die Dunkelfeld-Diagnose Hinweise, inwiefern eine Dysbiose, eine
Säure-Basen-Verschiebung oder eine durch Eiweißüberschuss
verursachte ( sog. Endobiose ) vorliegt.